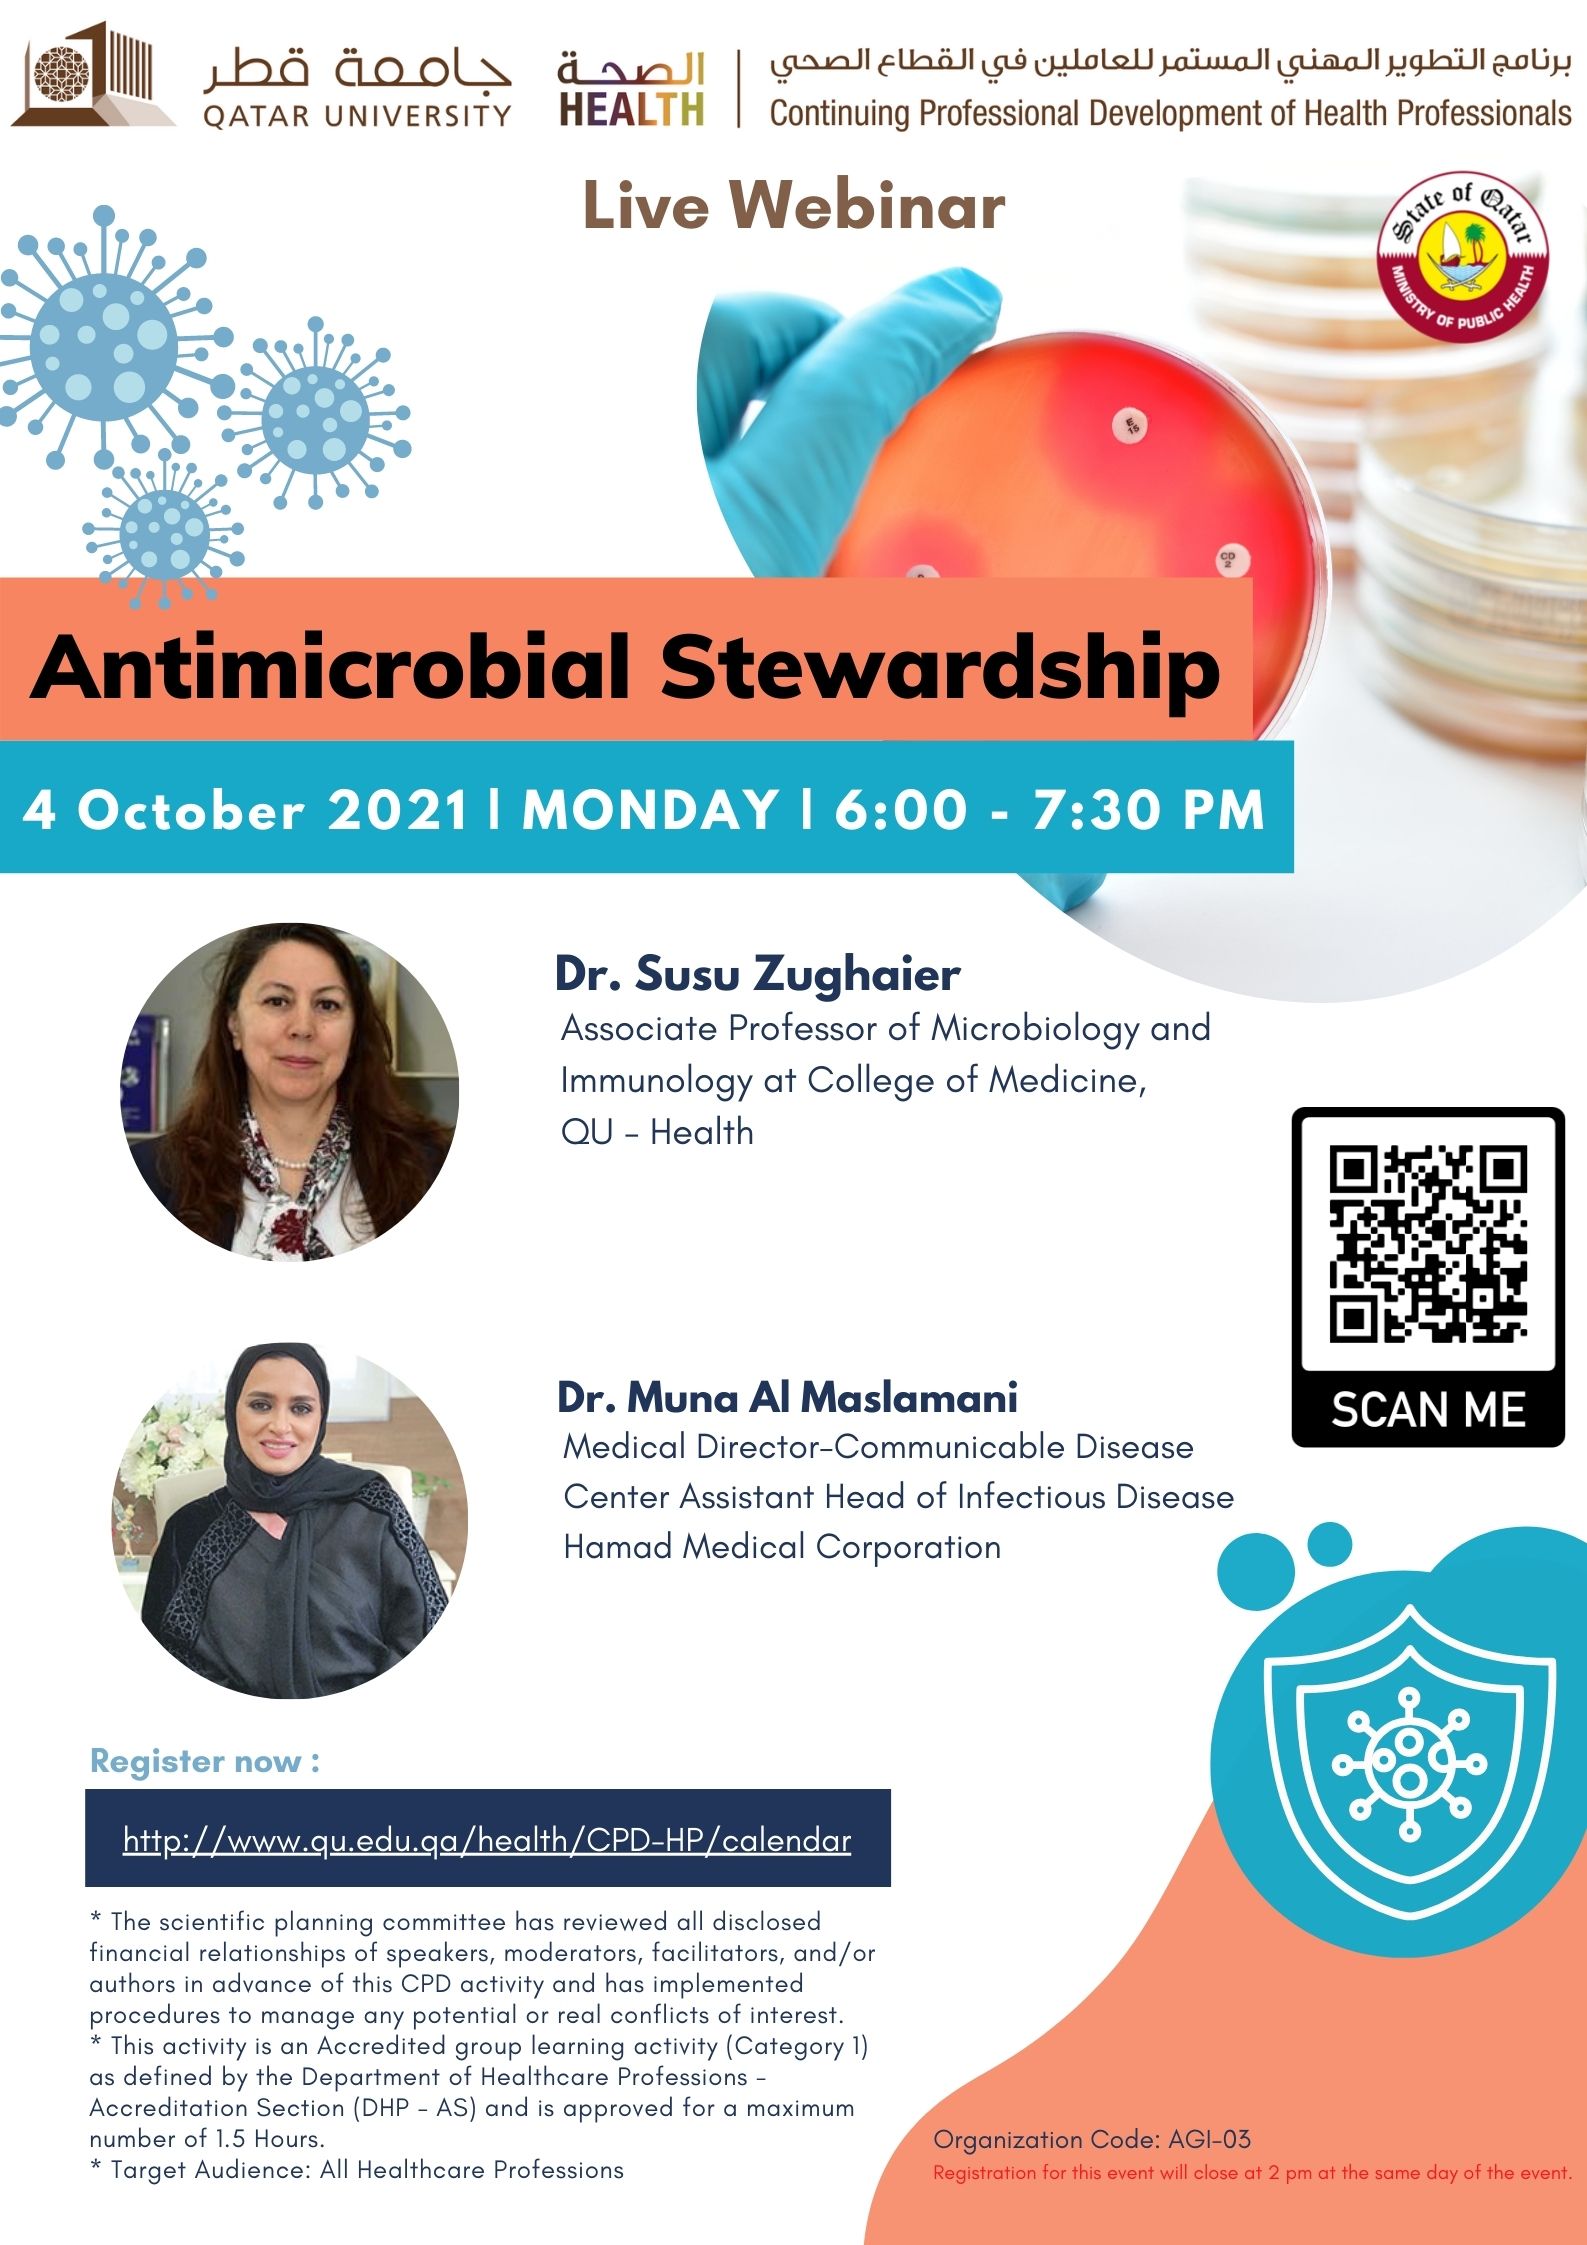
Antimicrobial Stewardship

| Vaccine and Community Health Monday, September 20, 2021 (06:00 PM - 07:30 PM)
 |
 | Asthma in Children, Diagnosis and Management, An Overview Monday, September 27, 2021 (06:00 PM - 07:30 PM)
 |
| Antimicrobial Stewardship Monday, October 4, 2021 (06:00 PM - 07:30 PM)
 |
 | COVID Associated Thrombosis: From Prevention to Treatment Monday, October 18, 2021 (06:00 PM - 07:30 PM)
 |
 | Common Misconceptions: Nutrition and Sports Monday, November 1, 2021 (06:00 PM - 07:30 PM)
 |
.jpg) | Graphene for Biomaterials and Craniofacial Tissue Engineering Thursday, November 4, 2021 (12:30 PM - 01:30 PM)
 |
 | Communication Skills in Clinical Practice: Healthcare Practitioner – Patient Communication Monday, November 15, 2021 (06:00 PM - 07:30 PM)
 |
 | Pain management: A Practice Update Monday, November 29, 2021 (06:00 PM - 07:30 PM)
 |
 | Parkinson’s Disease – A Local Perspective Monday, December 6th, 2021 (06:00 PM - 07:30 PM)
 |